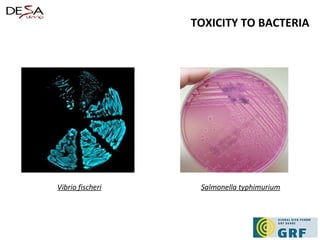
TOXICITY TO BACTERIA Vibrio fischeri Salmonella typhimurium

This document discusses various biological methods for assessing the quality of industrial effluents, including their advantages and limitations. It identifies common toxicity tests that use organisms like algae, microcrustaceans, fish, and bacteria to test the acute and chronic effects of effluents. The tests are standardized but no one test is best - a set of tests is recommended to understand effluent impacts. While standardized organisms are common, native species may also be used. The methods allow preventative evaluation of environmental impacts from effluents.